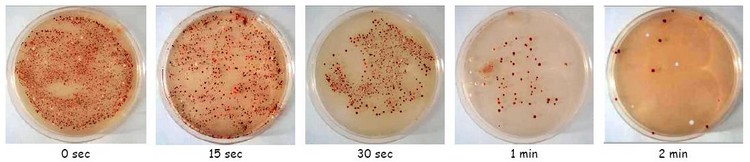

|
|
Chapitre 2 : Unité et diversité au niveau de l'Information Génétique |
Diapo à présenter : Visualisation de diapositives montrant le matériel génétique au cours du cycle cellulaire.
Chromosome : filament plus ou moins épais, généralement observé au niveau du noyau, dans la cellule en division.
|
Notion : Le matériel génétique est contenu dans un ou des chromosomes. |
On observe des chromosomes chez différentes espèces mais parfois ils disparaissent. Pourtant l’activité cellulaire, sous contrôle génétique, persiste.
Problème 1 : Quel est le support permanent et universel de l’Information Génétique ?
I – Le support de l'Information Génétique
Hypothèse(s) : L’ADN est le support universel de l’Information Génétique.
Si l’ADN est le support universel de l’Information Génétique, alors on doit pouvoir le mettre en évidence chez plusieurs espèces.
A/ La recherche d'ADN chez différentes espèces
Activité : Extraction de la molécule d’ADN de différentes espèces et schématisation du protocole expérimental.
--> Pistes d'exploitations : schématisation des étapes du protocole, capacités expérimentales...


Le réactif de Schiff colore la molécule d’ADN en fuschia. L’extraction met en évidence un filet blanchâtre qui se colore en fuschia : c’est l’ADN.
ADN : Acide désoxyribonucléique
L’ADN est présent chez l’oignon, le kiwi, la banane... Il est présent aussi chez toutes les espèces. L’hypothèse selon laquelle l’ADN est le support universel de l’Information Génétique est acceptée.
|
Notion : L’ADN est le support de l’Information Génétique. |
Gène : Portion d’ADN qui commande l’expression d’un caractère héréditaire précis.
Sur les chromosomes, il y a de nombreux gènes qui codent pour de nombreux caractères (= protéines).

Phénotype : Ensemble de caractères observables chez un individu. Génotype : Ensemble de l’information génétique d’un individu.
Si l’ADN est le support universel de l’Information Génétique, alors on doit pouvoir prélever le gène d’un individu codant pour un caractère et le transférer à un autre individu qui doit lui aussi exprimer ce caractère.
B/ Le résultat du transfert de gènes
Activité : Construction d'un schéma.

Expérience de Transgenèse
La transgenèse est une technique qui permet le transfert d’un gène – donc d’un caractère – d’un individu à un autre.
|
Notion : La transgenèse repose sur l’universalité de la molécule d’ADN en tant que support de l’Information Génétique. |

Problème 2 : Comment la molécule d’ADN peut-elle porter une information génétique ?
II – Le codage de l'Information Génétique sur la molécule d'ADN
Pour savoir comment la molécule peut porter une information génétique, il faut chercher dans sa structure ce qui permet ce codage.
A/ La constitution de la molécule d'ADN
Activité : Exercice ou document sur la constitution de la molécule d’ADN.
|
Notion : L’ADN est constitué de nucléotides à Adénine (A), Thymine (T), Guanine (G) et Cytosine (C). |
B/ L'organisation de la molécule d'ADN et le langage génétique
Activité : Visualisation de la molécule d’ADN à partir du logiciel Cellule 3D.
Activité : Construction d’une maquette de la molécule d’ADN.

Activité : Schéma de la molécule d’ADN à compléter.

Représentation schématique de la structure moléculaire de l’ADN

|
Notion : La molécule d’ADN est constituée de deux chaînes (= brins) complémentaires de nucléotides, disposés en double hélice. Une suite de nucléotides constitue une séquence. |
Revenir au problème 2
Hypothèse(s) : L’ordre des bases constitue un message.
Allèles : différentes versions d’un même gène.

Si l’ordre des bases constitue un message, alors en comparant deux allèles d’un même gène on doit trouver une différence dans l’ordre des bases.
Documents page 233 Belin : Séquence d'une partie du gène codant pour la chaîne bêta de l'hémoglobine humaine.
Quand on compare les séquences des allèles du gène codant pour l’hémoglobine (une protéine), on s’aperçoit que les deux séquences sont différentes. Les allèles d’un même gène ont une séquence différente. L’hypothèse selon laquelle l’ordre des bases constitue un message est acceptée.
|
Notion : La séquence des nucléotides d’un gène constitue un message. |
Problème 3 : Comment le code sur l’ADN peut-il être modifié ?
III – La variabilité de la molécule d'ADN
A/ L'origine génétique de la variabilité
Hypothèse(s) : Les mutations sont à l’origine de la modification de la séquence nucléotidique.
Documents page 233 Belin : Séquence d'une partie du gène codant pour la chaîne bêta de l'hémoglobine humaine.
C’est la version mutée du gène codant pour l’hémoglobine qui modifie la forme de l’hématie chez les patients atteints de drépanocytose.
Mutation : modification de la séquence nucléotidique d’un gène.
Exemple : MONDE et MO_DE / FEUILLE et FOUILLE
|
Notion : Les allèles ont pour origine les mutations qui modifient les séquences de l’ADN et qui introduisent une variabilité dans l’information génétique. |
B/ Les agents responsables de l'introduction de mutations
Hypothèse(s) :
H1 : Les UV peuvent augmenter le taux de mutations et modifier l’information génétique. H2 : Les radiations nucléaires peuvent augmenter le taux de mutations et modifier l’information génétique.
Si les UV augmentent le taux de mutation, alors en exposant des levures à un rayonnement ultra violet variable, on doit observer des modifications morphologiques.
Activité : Mise en culture de levures et exposition aux UV.
--> Pistes d'exploitations : comptage des colonies mutantes, construction d'un tableau, graphique...
Résultats la semaine suivante (photographies personelles).
Photos au format pdf (télécharger).

Activité : Remplissage d’un schéma explicatif.

Des mutations peuvent survenir de manière spontanée (cf. témoin). Cependant, les UV sont des agents mutagènes : ils augmentent le taux de mutation sur l’ADN. L’hypothèse selon laquelle les UV peuvent augmenter le taux de mutations et modifier l’information génétique est acceptée.
Revenir sur l’hypothèse H2.
Document 5 page 235 Belin : Texte sur la catastrophe nucléaire de Tchernobyl.
Activité : Réalisation d’un schéma.

Conséquences des agents mutagènes sur les cellules somatiques et germinales
L’hypothèse selon laquelle les radiations nucléaires peuvent augmenter le taux de mutations et modifier l’information génétique est acceptée. Les mutations qui touchent les cellules germinales sont transmissibles à la descendance, contrairement aux mutations qui affectent les cellules somatiques.
|
Notion : Certains agents de l’environnement (UV, rayonnement nucléaire...) peuvent augmenter le taux de mutation. Les conséquences des mutations sont différentes selon qu’elles touchent les cellules somatiques ou les cellules germinales. |
CONCLUSION
La molécule d’ADN présente une organisation et un fonctionnement universel au sein du monde vivant. Elle comporte de nombreux gènes dont la séquence représente des messages. Sa variabilité a pour origine des mutations sur cette séquence.
Retrouve-t-on ces similitudes au niveau de l’organisme entier ?
|